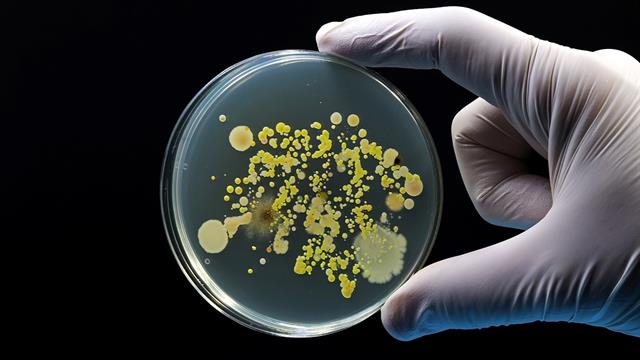
ECDC: Σοβαρή αύξηση κρουσμάτων λιστερίωσης στην Ευρώπη - Οδηγίες προστασίας

Η αλλαγή στη διατροφή και η γήρανση του πληθυσμού, ενδέχεται να συμβάλλουν στην αύξηση των σοβαρών λοιμώξεων από λιστέρια σε όλη την Ευρώπη.
Αυτό προκύπτει, μεταξύ άλλων, από νέα έκθεση της ΕΕ για τις ζωονόσους με τίτλο "Μία υγεία", όπως επισημαίνεται σε σημερινή αναφορά του Ευρωπαϊκού Κέντρου Ελέγχου Νοσημάτων (ECDC).
Σύμφωνα με τους ειδικούς του Κέντρου, κάθε χρόνο, χιλιάδες άνθρωποι σε όλη την Ευρώπη αρρωσταίνουν, μετά την κατανάλωση μολυσμένων τροφίμων, με τα αυγά, το κρέας και τα έτοιμα προς κατανάλωση τρόφιμα να συγκαταλέγονται στις πιο συχνές πηγές μόλυνσης.
Η έκθεση δείχνει ότι ενώ τα πρότυπα ασφάλειας των τροφίμων στην Ευρώπη παραμένουν υψηλά, οι τροφιμογενείς ασθένειες συνεχίζουν να επηρεάζουν άτομα όλων των ηλικιακών ομάδων - ειδικά εκείνες που είναι πιο ευάλωτες σε σοβαρές ασθένειες - παρόλο που πολλές από αυτές τις ασθένειες μπορούν να προληφθούν.
Το 2024, η λιστέρια προκάλεσε το υψηλότερο ποσοστό νοσηλειών και θανάτων μεταξύ όλων των τροφιμογενών λοιμώξεων που αναφέρθηκαν στην Ευρωπαϊκή Ένωση (ΕΕ). Περίπου 7 στα 10 άτομα που είχαν μολυνθεί, χρειάστηκαν νοσοκομειακή περίθαλψη και ένας στους 12 πέθανε.
Η ανοδική τάση των λοιμώξεων που παρατηρείται τα τελευταία χρόνια μπορεί να αντανακλά διάφορους παράγοντες, όπως η γήρανση του πληθυσμού της Ευρώπης, οι μεταβαλλόμενες διατροφικές συνήθειες - όπως η αυξανόμενη κατανάλωση έτοιμων προς κατανάλωση τροφίμων - καθώς και οι ακατάλληλες πρακτικές χειρισμού και αποθήκευσης τροφίμων.
Για τα έτοιμα προς κατανάλωση τρόφιμα, τα επίπεδα μόλυνσης παραμένουν πολύ χαμηλά στις περισσότερες κατηγορίες: τα τελευταία δεδομένα για τη Listeria monocytogenes δείχνουν ότι το ποσοστό των δειγμάτων που υπερβαίνουν τα όρια ασφάλειας τροφίμων της ΕΕ κυμαινόταν από 0% έως 3% σε όλα τα προϊόντα που αναλύθηκαν, με τα λουκάνικα που έχουν υποστεί ζύμωση να είναι τα προϊόντα που μολύνθηκαν συχνότερα.
"Παρόλο που η μόλυνση είναι σπάνια, η λιστέρια μπορεί να προκαλέσει σοβαρή ασθένεια, γεγονός που την καθιστά μία από τις πιο σοβαρές τροφιμογενείς απειλές που παρακολουθούμε", δήλωσε ο Ole Heuer, επικεφαλής της Μονάδας Νοσημάτων που Σχετίζονται με την Υγεία του ECDC. "Η προστασία των ευάλωτων σε αυτές τις ασθένειες ομάδων, όπως οι ηλικιωμένοι, οι έγκυες γυναίκες ή τα άτομα με εξασθενημένο ανοσοποιητικό σύστημα, απαιτεί ισχυρή επιτήρηση, ασφαλή παραγωγή τροφίμων και βασικές προφυλάξεις στο σπίτι".
Συχνές τροφιμογενείς λοιμώξεις
Ενώ η λιστέρια ενέχει τον μεγαλύτερο κίνδυνο σοβαρής ασθένειας, το καμπυλοβακτήριο και η σαλμονέλα παραμένουν οι πιο συχνές αιτίες τροφιμογενών νοσημάτων στην Ευρώπη, με το κρέας και τα αυγά πουλερικών να αποτελούν σημαντικές πηγές μόλυνσης.
Πρόσφατα δεδομένα στον τομέα των ζώων δείχνουν επίσης σημαντική αύξηση την τελευταία δεκαετία σε κοτόπουλα αναπαραγωγής και γαλοπούλες που βρέθηκαν θετικά σε σαλμονέλα. Ο έλεγχος αυτών των βακτηρίων στην τροφική αλυσίδα παραμένει απαραίτητος για τη μείωση των κρουσμάτων σε ανθρώπους:
"Φέτος, ένας σημαντικός αριθμός χωρών της ΕΕ δεν κατάφερε να επιτύχει όλους τους στόχους για τη μείωση της σαλμονέλας στα πουλερικά, με μόνο 14 κράτη μέλη να έχουν επιτύχει πλήρη συμμόρφωση", δήλωσε ο Frank Verdonck, επικεφαλής της Μονάδας Βιολογικών Κινδύνων και Υγείας και Ευημερίας των Ζώων της EFSA. "Αυτό μας υπενθυμίζει ότι ο έλεγχος των τροφιμογενών βακτηρίων κατά μήκος της τροφικής αλυσίδας απαιτεί συνεχή προσπάθεια και συντονισμό σε όλους τους τομείς".
Μπορούν να προληφθούν
Η τήρηση των κατάλληλων πρακτικών υγιεινής τροφίμων στην κουζίνα μπορεί να βοηθήσει τους ανθρώπους να μειώσουν σημαντικά τον κίνδυνο μόλυνσης. Αυτές οι πρακτικές περιλαμβάνουν:
- Διατήρηση της θερμοκρασίας στο ψυγείο στους 5°C ή χαμηλότερα.
- Κατανάλωση τροφίμων, συμπεριλαμβανομένων των έτοιμων προς κατανάλωση προϊόντων, πριν από την ημερομηνία λήξης.
- Καλό μαγείρεμα των τροφίμων, ειδικά του κρέατος και των πουλερικών.
- Πλύσιμο χεριών, μαχαιριών και επιφανειών μετά τον χειρισμό ωμών τροφίμων.
- Διατήρηση μαγειρεμένων τροφίμων χωριστά από ωμά προϊόντα.
Οι ευάλωτες ομάδες θα πρέπει να αποφεύγουν την κατανάλωση τροφίμων υψηλού κινδύνου, όπως έτοιμα προς κατανάλωση προϊόντα, μη παστεριωμένο γάλα και μαλακά τυριά που παρασκευάζονται από αυτό.
Προσθέστε το iatronet.gr στο DiscoverΕιδήσεις υγείας σήμερα
Πέρα δώθε
Ρεκόρ θερμοκρασίας στη Βρετανία τον Ιούνιο
Τριμάρισμα βλεφαρίδων: Άλλο ένα ανεκδιήγητο trend του TikTok
ΕΟΔΥ: Σε άνοδο η λιστερίωση στην Ευρώπη: Συμπτώματα, πρόληψη, προστασία των ευπαθών ομάδων
ΕΟΔΥ: Σε άνοδο η λιστερίωση στην Ευρώπη: Συμπτώματα, πρόληψη, προστασία των ευπαθών ομάδων ECDC: Κρούσματα λιστερίωσης σε επτά ευρωπαϊκές χώρες από προϊόντα ψαριού
ECDC: Κρούσματα λιστερίωσης σε επτά ευρωπαϊκές χώρες από προϊόντα ψαριού ECDC: Κρούσματα λιστερίωσης απο καπνιστό σολομό σε τρεις χώρες
ECDC: Κρούσματα λιστερίωσης απο καπνιστό σολομό σε τρεις χώρες Κρούσματα λιστερίωσης από τυρί στη Γαλλία - Πρόωροι τοκετοί σε εγκύους
Κρούσματα λιστερίωσης από τυρί στη Γαλλία - Πρόωροι τοκετοί σε εγκύους ECDC: Συρροές κρουσμάτων λιστερίωσης σε 5 ευρωπαϊκές χώρες - Πού αποδίδονται
ECDC: Συρροές κρουσμάτων λιστερίωσης σε 5 ευρωπαϊκές χώρες - Πού αποδίδονται  Αποσύρεται ανθότυρο με Listeria
Αποσύρεται ανθότυρο με Listeria Τριμάρισμα βλεφαρίδων: Άλλο ένα ανεκδιήγητο trend του TikTok
Τριμάρισμα βλεφαρίδων: Άλλο ένα ανεκδιήγητο trend του TikTok Καροτιναιμία: Τι είναι και μπορεί να μας κάνει κακό;
Καροτιναιμία: Τι είναι και μπορεί να μας κάνει κακό; 5λεπτα διαλείμματα για περπάτημα ενισχύουν τη διάθεση και μειώνουν την κόπωση
5λεπτα διαλείμματα για περπάτημα ενισχύουν τη διάθεση και μειώνουν την κόπωση Χαμηλή πίεση και Alzheimer: Τι αποκαλύπτει νέα μελέτη
Χαμηλή πίεση και Alzheimer: Τι αποκαλύπτει νέα μελέτη Με ποιες τροφές να συνδυάζω ρύζι, πατάτες και ζυμαρικά για να μην αυξάνεται απότομα το σάκχαρο
Με ποιες τροφές να συνδυάζω ρύζι, πατάτες και ζυμαρικά για να μην αυξάνεται απότομα το σάκχαρο Ρύζι, πατάτες και ζυμαρικά: Ποιο είναι χειρότερο για το σάκχαρο;
Ρύζι, πατάτες και ζυμαρικά: Ποιο είναι χειρότερο για το σάκχαρο; Pharmathen: Βαθιά κρίση και μηδενισμός αποτίμησης από funds της Partners
Pharmathen: Βαθιά κρίση και μηδενισμός αποτίμησης από funds της Partners ΕΟΠΥΥ: Στο 1,1 δισ. ευρώ έκλεισαν clawback - rebate φαρμάκων το 2025 - Επίσημος απολογισμός
ΕΟΠΥΥ: Στο 1,1 δισ. ευρώ έκλεισαν clawback - rebate φαρμάκων το 2025 - Επίσημος απολογισμός Απ. Παπαλάκης: Ραγδαία αύξηση περιστατικών καρκίνου της ουροδόχου κύστης
Απ. Παπαλάκης: Ραγδαία αύξηση περιστατικών καρκίνου της ουροδόχου κύστης Συγκλονισμένοι οι υγειονομικοί από τον θάνατο 36χρονης γιατρού στη Μυτιλήνη
Συγκλονισμένοι οι υγειονομικοί από τον θάνατο 36χρονης γιατρού στη Μυτιλήνη Novo Nordisk Ελλάδος: Τιμήθηκε με το ‘’Σήμα Διαφορετικότητας’’ 2026 από το Υπουργείο Κοινωνικής Συνοχής & Οικογένειας
Novo Nordisk Ελλάδος: Τιμήθηκε με το ‘’Σήμα Διαφορετικότητας’’ 2026 από το Υπουργείο Κοινωνικής Συνοχής & Οικογένειας Καρπούζι: Ποια είναι τα οφέλη του στην υγεία
Καρπούζι: Ποια είναι τα οφέλη του στην υγεία